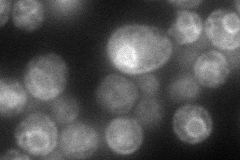
YER044C
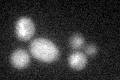
YER044C

View description
Endoplasmic reticulum membrane protein, may facilitate protein-protein interactions between the Erg26p dehydrogenase and the Erg27p 3-ketoreductase and/or tether these enzymes to the ER, also interacts with Erg6p
Localization:
Intensity:
Fold change:
Significance:
-
C’ GFP library in SD

below threshold18.55 -
N' NOP1pr-GFP in SD
ER84.7651 -
N' TEF2pr-mCherry in SD

ER194.263 -
N' NATIVEpr-GFP in SD

ER30.3007 -
N' TEF2pr-VC and Cyto-VN in SD

below threshold24.2057 -
C’ GFP library in SD+DTT
cytosol16.770.9No -
C’ GFP library in SD+H2O2

cytosol15.850.85No -
C’ GFP library in Starvation Media

cytosol13.530.72No -
C’ GFP library on the background of Pup2-DaMP

below threshold -
C’ GFP library on the background of CCT mutant

below threshold16.28730.877828No
